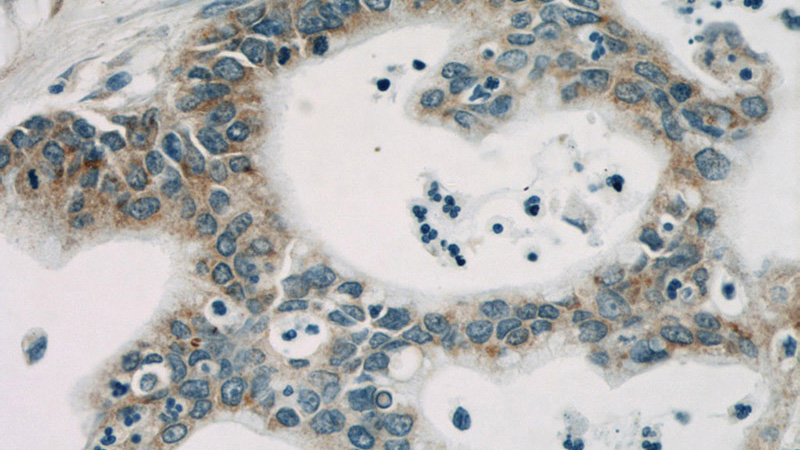
Immunohistochemical of paraffin-embedded human pancreas cancer using Catalog No:107225(PPIB antibody) at dilution of 1:50 (under 40x lens)

-
Product Name
Cyclophilin B antibody
- Documents
-
Description
Cyclophilin B Mouse Monoclonal antibody. Positive IHC detected in human pancreas cancer. Positive WB detected in Hela cells, HepG2 cells, U-937 cells. Observed molecular weight by Western-blot: 24kD
-
Tested applications
ELISA, WB, IHC
-
Species reactivity
Human; other species not tested.
-
Alternative names
Cyclophilin B antibody; CYP S1 antibody; CYPB antibody; PPIase B antibody; Rotamase B antibody; S cyclophilin antibody; SCYLP antibody
-
Isotype
Mouse IgG2a
-
Preparation
This antibody was obtained by immunization of Cyclophilin B recombinant protein (Accession Number: NM_000942). Purification method: Protein A purified.
-
Clonality
Monoclonal
-
Formulation
PBS with 0.02% sodium azide and 50% glycerol pH 7.3.
-
Storage instructions
Store at -20℃. DO NOT ALIQUOT
-
Applications
Recommended Dilution:
WB: 1:500-1:5000
IHC: 1:20-1:200
-
Validations

HeLa cells were subjected to SDS PAGE followed by western blot with Catalog No:107225(PPIB antibody) at dilution of 1:1000

Immunohistochemical of paraffin-embedded human pancreas cancer using Catalog No:107225(PPIB antibody) at dilution of 1:50 (under 10x lens)
Immunohistochemical of paraffin-embedded human pancreas cancer using Catalog No:107225(PPIB antibody) at dilution of 1:50 (under 40x lens)
-
Background
PPIB, also named as CYPB, SCYLP, PPIase B and CYP-S1, belongs to the cyclophilin-type PPIase family and PPIase B subfamily. PPIases accelerate the folding of proteins. It catalyzes the cis-trans isomerization of proline imidic peptide bonds in oligopeptides. PPIB is secreted in biological fluids such as blood or milk and binds to a specific receptor present on the human lymphoblastic cell line Jurkat and on human peripheral blood lymphocytes.
Related Products / Services
Please note: All products are "FOR RESEARCH USE ONLY AND ARE NOT INTENDED FOR DIAGNOSTIC OR THERAPEUTIC USE"
